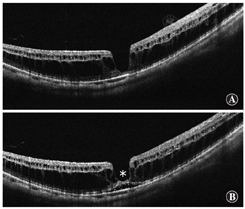
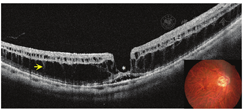

在世界范围内,病理性近视是视力损害的主要原因。病理性近视与高度近视有明显差异。高度近视是指高度近视性屈光不正,而病理性近视是指眼底存在典型的并发症(相当于或比弥漫性脉络膜萎缩更严重的后巩膜葡萄肿或近视性黄斑病变)。病理性近视通常发生在高度近视眼,但其并发症,特别是后巩膜葡萄肿,也可能发生在非高度近视眼中。由于近年来眼科成像技术的进展,客观和准确地诊断病理性近视已成为可能。特别是光学相干断层扫描发现了一些新的病变,如圆顶状黄斑和近视牵引性黄斑病变。广域光学相干断层扫描已能成功地显示大葡萄肿的整个范围。针对并发症的新疗法已经被证明是有效的,如抗血管内皮生长因子治疗近视性黄斑新生血管和玻璃体视网膜手术治疗近视牵引性黄斑病变。近视,特别是儿童近视,在世界范围内呈快速增长趋势。在近视增加的同时,高度近视的患病率也在增加。然而,尚不清楚病理性近视是否会随着近视发病率的增加而增加。此外,还不清楚的是导致病理性近视的基因是否与一般近视相同,或者病理性近视是否与其他近视在基因上有所不同。

版权归中华医学会所有。
未经授权,不得转载、摘编本刊文章,不得使用本刊的版式设计。
除非特别声明,本刊刊出的所有文章不代表中华医学会和本刊编委会的观点。
根据国际近视研究院的定义[1],病理性近视是一种与近视相关的过度眼轴增长,导致眼球后段结构变化(包括后巩膜葡萄肿、近视性黄斑病变和高度近视相关性视神经病变),并可致最佳矫正视力下降。术语"病理性近视"经常与"高度近视"混淆。高度近视定义为高度的近视性屈光不正;而"病理性近视"的特征是在眼底后极部存在典型的近视病变。Duke-Elder[2]将病理性近视定义为"伴有退行性变化的近视,特别是发生于眼底后极部的病变。"
眼底后极部特征性近视病变包括近视性黄斑病变,相当于或严重于弥漫性脉络膜视网膜萎缩[相当于病理性近视Meta分析(META-PM)分类中的第2类][3]和/或存在后巩膜葡萄肿[4]。近视性屈光不正度数和眼轴长度阈值不能区分病理性近视,因为后巩膜葡萄肿也发生在眼轴长度正常[5]或小于26.5 mm[6]的眼中,尽管长眼轴是眼底并发症的危险因素之一。
因为黄斑区进行性脉络膜变薄和Bruch膜逐渐受损是与近视性黄斑病变相关的关键表现,所以通过光学相干断层扫描(optical coherence tomography,OCT)获得的图像比眼底照片能更好地对近视性黄斑病变进行分类[7]。
据报道,病理性近视影响多达3%的世界人口,其患病率存在种族差异[8]。1%~3%的亚洲人和1%的白种人患有病理性近视。然而,早期研究中对病理性近视的定义并不一致,将病理性近视与高度近视混淆。因此,需要根据病理性近视新的标准定义来确定准确的患病率。
病理性近视导致0.2%~1.5%的亚洲人和0.1%~0.5%的白种人视力受损或盲[8],特别是在劳动力人口和老年人口中,其是低视力的主要原因之一。在亚洲的日本、中国大陆和中国台湾,病理性近视是不可逆盲的主要原因。在中国台湾,病理性近视是65岁及以上人群视力受损的第二大原因[9]。在日本,病理性近视是造成双眼低视力的第三大原因,也是40岁及以上人群单眼盲的主要原因[10]。中国40~49岁人群中,病理性近视是盲和低视力的主要原因[11]。根据鹿特丹研究、哥本哈根城市眼科研究和洛杉矶拉丁裔眼科研究,在西方国家,病理性近视是盲的第三大病因[12,13,14]。
近年来,由于环境和生活方式等因素的改变,近视和高度近视的患病率迅速升高。因此,病理性近视相关的患病率在不久的将来也可能显著升高。
屈光度不小于-5.00 D可以定义为高度近视[15],其与病理性近视相关。大多数病理性近视发生于高度近视患者,但低度近视和一些正视眼也会发展成病理性近视。新加坡、澳大利亚、日本、中国农村、中国南部、中国台湾和北京的成年和老年高度近视患者中,分别有28.7%、44.4%、45.9%、47.6%、58.31%、72.7%和65%的人口患有病理性近视[9,16,17,18,19,20,21]。意味着成年人群中约50%的高度近视受试者会发展为病理性近视。
高度近视的患病率与近视的总体患病率有关。中国台湾18岁人群近视患病率高达84%,高度近视患病率约为21%[22]。2000年,全球约22.9%的人口被诊断为近视,其中11.6%为高度近视。据估计,到2050年,全球约有50%的人口将患有近视,高达1/5的人口将患有高度近视[23]。因此,在近视患病率高的地区,高度近视和病理性近视的患病率也会增加。病理性近视将会导致大量患者视力受损,并将对社会产生重大的负面影响。
近视程度与病理性近视的风险相关。病理性近视在低到中度近视人群(-3 D)中的患病率仅为1%~19%,而在高度近视人群中患病率高达50%~70%[17,18,24]。近视屈光度增加1 D,病理性近视患病率增加67%[25]。在近视增加到-7.00 D前,病理性近视患病率呈线性增长趋势,之后呈指数增长趋势[26]。
除近视程度外,年龄也是病理性近视发生的重要因素。在新加坡,近视性黄斑病变的患病率随等效球镜度数和年龄的增加呈指数增长[19]。病理性近视在儿童和青少年中的患病率较低,但随着年龄的增长而增加。在40岁及以上的高度近视患者中,黄斑病变的患病率和严重程度呈进行性增加。在中国和新加坡成年人高度近视人群中,分别有52.9%和19.3%的患者出现病理性近视改变并伴有脉络膜视网膜萎缩[27,28]。在中国台湾老年人中,近视性黄斑病变从65岁的2.2%增加到相对更年长人群的14.8%。近视性黄斑病变在高度近视儿童中罕见[29]。然而,一项长期随访研究显示,83%患有病理性近视和近视性黄斑病变的成年人在童年时已有视盘周围弥漫性脉络膜萎缩[30]。这一发现表明,最终发展为病理性近视的儿童在很小的时候眼底就可能不同。
近视有2种类型——先天性近视或婴儿性近视以及后天获得性近视或上学后近视。先天性近视具有家族聚集性,受遗传因素的影响较大。然而,先天性近视的患病率较低,在白种人中不到1%[31]。婴儿性近视的初始近视程度往往很高,并可观察到近视进展[32]。病理性近视的患病率较高可能与高度近视人群寿命较长有关。
排除了具有很强家族遗传性的先天性近视后,后天获得性或上学后近视发生在小学或初中早期[33]。值得注意的是,从6岁开始到青春期结束,近视儿童每年近视度数约进展1 D,而在11~13岁时发展为高度近视[34]。鉴于全世界近视儿童的激增,与视力损害相关的病理性近视的严重程度可以预见。
在获得性近视的病例中,由于在不同地区有不同的患病率差异,可能存在遗传易感性。尽管已经发现超过200个基因变异与近视相关,但没有1个基因变异主要导致获得性近视[35]。因此,环境因素在近视和高度近视的发展中起着更为重要的作用,风险因素主要包括教育压力、近距离工作时间和强度以及缺少户外活动时间[36,37]。此外,智能手机时代带来的数字屏幕使用时间的增加,以及2019年新型冠状病毒全球流行带来的在线教育的普及,可能会在不久的将来加剧近视的流行[38]。
全基因组关联研究(genome-wide association studies,GWASs)已确定了数百个近视易感基因[39,40,41,42,43,44]。然而,病理性近视的遗传背景尚未完全阐明。例如,对于是否所有高度近视受试者都有相同的病理性近视风险,或者病理性近视的风险是否取决于患者的遗传背景仍知之甚少。
一些研究调查了近视性黄斑新生血管增生(macular neovascularization,MNV)与近视、高度近视和年龄相关性黄斑变性(age-related macular degeneration,AMD)的易感基因之间的关系。在AMD易感基因及其相关基因中,评估了ARMS2、CFH、C2/CFB、C3、CFI、ABCA1、APOE、LIPC、CETP、TIMP3、COL8A1、COL10A1、VEGFA、PEDF与MNV的相关性[45,46,47,48,49,50]。CFI、COL8A1和PEDF被认为是MNV的易感基因,有报道称VEGFA与MNV受累面积和MNV治疗后的视力预后相关[47,51]。然而,这些关联在后来的研究中未得到证实。在近视和高度近视的易感基因中,对GJD2、RASGRF1、TOX、RDH5和SHISA6与MNV的相关性进行了评估,但未发现联系[52,53]。
2015年,提出了一套近视性黄斑病变的图片分类分级体系[3]。此后,近视性黄斑病变分类系统(META-PM分类法)被用于研究病理性近视。2019年,有研究对348例高度近视伴有近视性黄斑病变和898例高度近视未伴有近视性黄斑病变患者的50个近视易感基因的基因型分布进行了比较,但均未发现高度近视的易感基因与近视性黄斑病变存在显著相关性[54]。
2018年,一项关于日本人群中近视性黄斑病变的GWASs研究发现,CCDC102B是近视性黄斑病变的易感基因[55]。在1 381例高度近视合并近视性黄斑病变患者和936例未合并近视性黄斑病变的高度近视对照者中,CCDC102B基因型分布有显著性差异。然而,CCDC102B与眼轴长度无显著相关性,既往关于近视的GWASs报道也未发现CCDC102B与近视有任何相关性。因此,CCDC102B是近视性黄斑病变的易感基因,但不是近视的易感基因。鉴于近视遗传因素和近视性黄斑病变遗传因素不同,我们将能够研发出预防近视性黄斑病变的方法,甚至惠及已患有近视或高度近视的患者。当然,CCDC102B在近视性黄斑病变发展中的作用仍有待阐明。
CCDC102B的发现表明,我们可能能够预防近视性黄斑病变的发展,甚至在高度近视发生之后。为了控制高度近视患者病理性近视的发展,需要进一步研究发现更多与高度近视无关的近视性黄斑病变的易感基因。因为高度近视的后巩膜葡萄肿与近视性黄斑病变有关,识别后巩膜葡萄肿和/或眼后极部形态的易感基因也有助于今后控制病理性近视的发展。OCT可以定量评估后极部眼底的形态[56]。对于眼底形态的GWASs可能能够发现与眼底形态和/或葡萄肿相关的基因,有助于今后控制病理性近视的发展。
自从1977年Wiesel和Raviola[57]发现眼睑缝合的猴眼轴会增长后,动物模型一直是了解近视和研究近视治疗的重要工具。本节总结了自发或通过单眼剥夺出现病理性近视特征的动物模型。
在Embase数据库中逐一使用以下关键词:"动物模型"、"后巩膜葡萄肿"、"漆裂纹"、"近视性黄斑病变"、"脉络膜新生血管"和"Fuchs斑"单独搜索后,有1 502个检索结果。"脉络膜新生血管"的条目有1 466条,这些脉络膜新生血管几乎完全是通过激光光凝术人工诱导的,因此被排除。筛选结果总结见表1,包括视网膜病变、眼球增大的鸡(rge)、正常对照鸡和LRP2敲除小鼠。

自发出现或单眼形觉剥夺诱导出病理性近视特征的动物模型总结
自发出现或单眼形觉剥夺诱导出病理性近视特征的动物模型总结
| 作者 | 年份 | 动物模型 | 样本量 | 相关表型 | 方法 | 干预开始时间(d) | 诱导近视的程度 | 其他特征 |
|---|---|---|---|---|---|---|---|---|
| Cases等[95] | 2015 | 小鼠 | 20 | 21 d后视盘周围出现葡萄肿,60 d后出现脉络膜视网膜萎缩 | LRP2敲除动物模型自发发生。Stickler综合征相关的变异和Donnai-Barrow或面-声-肾综合征(DBS/FOAR)会出现眼部损伤 | 0 | 90 d:大约40%眼轴增长 | 玻璃体腔增大,视网膜变薄(由于细胞死亡),巩膜后极部变薄,胶原纤维很少形成板层结构 |
| Wen等[295] | 2006 | 鸡 | 45 | 12周后出现漆裂纹 | 眼睑缝合的形觉剥夺 | 2 | 4周:(-10.23±2.15)D;8周:(-15.57±2.52)D;12周:(-17.01±3.29)D;眼轴长度分别增加了13.5%,11.4%,11.1% | 无 |
| Hirata和Negi[72] | 1998 | 鸡 | 40 | 8周后出现漆裂纹,4周后出现脉络膜视网膜萎缩(脉络膜毛细血管层显著变薄) | 眼睑缝合的形觉剥夺 | 1 | 8周:28.3%眼轴增长 | 无 |
| Montiani-Ferreira等[76] | 2004 | 鸡 | 9 rge/rge,12 rge/+,5+/+ | 6.4周后出现漆裂纹,134周后出现局灶性脉络膜视网膜萎缩和巩膜移位 | 先天性静止性夜盲模型(GNB3基因变异)自发发生。全眼球扩大视网膜病变(rge)鸡模型 | 0 | 远视。在92 d rge/rge为(-9.8±7.4)D,rge/+为(4.3±0.57)D,眼轴长度增加了14.8% | Bruch膜撕裂区RPE局部缺失,异常的Bruch膜和脉络膜毛细血管表面覆盖RPE纤维母细胞 |
| Mao等[296] | 2006 | 鸡 | 32 | 12周后出现脉络膜视网膜萎缩 | 眼睑缝合的形觉剥夺 | 1 | 12周:(-18.0±2.25)D,23.1%眼轴增长 | 在近视鸡眼的外核层和内核层有TUNEL染色阳性细胞 |
注:RPE:视网膜色素上皮
小鼠模型被广泛使用是因为其遗传学和生理学都被了解得很清楚[58]。与人类相似,小鼠巩膜和成纤维细胞含有5种类型的毒蕈碱受体[59,60]。然而,小鼠是夜行动物,缺乏黄斑中央凹和调节能力[61]。此外,其晶状体比人类晶状体更接近球形,占据了大部分的玻璃体腔[62]。
鸡的眼球较大,占头颅容积的50%,而成人眼球仅占5%[63]。此外,鸡眼还含有梳状的血管结构眼果胶,为视网膜提供营养和氧气。最重要的是,鸡的巩膜上有软骨层和小骨,这与其他哺乳动物不同[64,65]。尽管如此,鸡的视网膜中央有1个没有视杆细胞的区域,该区域包含更密集的视锥光感受器,类似于人类的黄斑[66]。和老鼠一样,小鸡没有中央凹。
漆裂纹是黄斑区呈黄色的线状病变,OCT血管成像(OCT angiography,OCTA)下似乎缺乏脉络膜毛细血管层。漆裂纹见于4.3%~15.7%的病理性近视患者[67,68,69,70]。该病变被认为代表Bruch膜-RPE-脉络膜毛细血管层复合体的机械性断裂。在病理性近视中,漆裂纹通常出现在水平方向的颞侧到中央凹处[71]。人们可能会认为,由于Bruch膜内的水平张力可暂时由视盘旁γ区缓解,漆裂纹可以沿水平方向裂开,以缓解垂直方向过剩的张力。
鸡在孵化后第1天通过缝合眼睑进行单眼形觉剥夺,8周后出现类似漆裂纹的病变[72](图1A)。与人类相似,这些病变往往是水平方向的,这可能是由于视网膜垂直方向的梳状血管结构。血管铸型表明漆裂纹没有明显的分界线。中间有一间隙,缺乏Bruch膜和脉络膜毛细血管层。这一间隙被脉络膜毛细血管密度降低的区域所包围,可能是由于血管床张力增加导致的萎缩(图1B)。此外,还可以看到大的脉络膜血管跨过间隙。RPE的增生和集聚(图1C),表明漆裂纹已经形成了一段时间,RPE有足够的时间做出反应。


Rge鸡出现了进行性的早发性视力丧失和GNB3基因缺失,导致一种无功能的蛋白质生成。GNB3基因编码鸟嘌呤核苷酸结合蛋白b3(Gbeta3)[73]。生理上,Gbeta3是光传导级联的一部分,是ON型双极细胞中G蛋白信号途径中的组成部分[74]。GNB3基因变异可见于视网膜厚度正常的先天性静止性夜盲患者[75]。
Rge鸡在孵化后45 d就会出现漆裂纹[76](图2A)。组织学图片显示Bruch膜破裂,与周围结构完整的区域相比缺乏RPE(图2B)。


研究表明,病理性近视患者的漆裂纹往往因长度伸长、数量增加或进展为局限性萎缩而恶化[71,77,78]。有趣的是,鸡的模型也出现类似的进展模式。在图3中,与图2所示的8周龄鸡眼相比,50周龄的鸡眼睑缝合后出现了更多的漆裂纹和明显的眼轴伸长。虽然在长期观察眼睑缝合鸡的过程中未形成明显的局限性萎缩,但134周龄的rge鸡出现了类似局限性萎缩的环形病变(图3)。病变部位的OCT图像显示组织变薄和巩膜后弓状区域,这与病理性近视患者的局限性脉络膜视网膜萎缩相一致。这一发现表明,这2种特征可能具有相似的病理生理学特征,rge鸡可能是研究该病合适的动物模型。


后巩膜葡萄肿是一种眼球壁的局限性突起,其曲率半径小于周围眼壁的曲率[79]。约50%的病理性近视存在后巩膜葡萄肿,但其病因仍不祥[5]。研究表明,后巩膜葡萄肿继发于组织结构萎缩和胶原纤维改变导致的巩膜张力下降[80,81,82]。然而,巩膜加固产生了复杂结果[83,84,85,86],脉络膜也会变薄,因为其与后巩膜葡萄肿密切相关[87]。获得性脉络膜变薄者也显示眼轴变长,但未发展为后巩膜葡萄肿[88]。此外,视网膜色素变性患者可在脉络膜完整区形成后巩膜葡萄肿[89]。
Bruch膜是位于RPE和脉络膜之间的一种无细胞的5层的细胞外基质[90],其厚度为2~4 μm,促进脉络膜毛细血管层和RPE之间的营养物质和代谢产物运输,同时为眼球提供结构支持。葡萄肿边缘的Bruch膜及其周围结构变薄或缺失[91]。继发性Bruch膜缺损的眼可表现为侧方巩膜葡萄肿,如弓形虫性黄斑瘢痕[92]。此外,在轴向拉长的眼球中其他层变薄时,Bruch膜的厚度保持不变,Jonas等[93]提出Bruch膜可能在正视化、近视化和潜在葡萄肿的发展过程中发挥了积极作用。
如图3C所示,134周龄rge鸡的眼OCT图像显示,Bruch膜缺损区域巩膜向外隆起。由于巩膜移位的程度有限,很难断定这些巩膜变形一定是葡萄肿。然而,似乎有理由认为这可能是葡萄肿形成过渡的早期阶段。需要进行更长时间的观察,以监测巩膜变形的发展。
目前,低密度脂蛋白受体相关蛋白2(low-density lipoprotein receptor-related protein 2,LRP2)基因敲除小鼠动物模型确定会发生后巩膜葡萄肿[94]。LRP2编码巨蛋白——一种位于吸收上皮细胞顶端的跨膜受体,其调节某些循环化合物的水平,如脂蛋白、类固醇、维生素结合蛋白和激素[95]。LRP2基因突变与罕见的遗传疾病,如Donnaio-Barrow综合征和Stickler综合征有关,这2种疾病均表现为面部畸形、听力丧失、眼部缺陷和脉络膜视网膜萎缩[96]。
组织学切片和MRI检查显示,LRP2基因敲除小鼠模型分别在第15天和第21天出现眼轴增长和后巩膜葡萄肿(图4A,B)。脉络膜和RPE在葡萄肿边缘分离,这2层逐渐变薄,在进入视盘前消失。这些图像上不能清楚地识别Bruch膜。此外,视网膜明显变薄,在整个检测区域可见固缩的细胞体。这一发现表明,在这个模型中,有明显与视盘旁葡萄肿范围相对应的视盘旁萎缩区。这种构型与病理性近视患者的视盘周围γ区的后隆起相一致(图4C)[97]。


除了后巩膜葡萄肿,突变小鼠还发生视网膜和巩膜变薄以及脉络膜视网膜萎缩,类似于病理性近视患者。此外,LRP2基因敲除小鼠在一生中保持了恒定的眼压,这也与病理性近视患者的研究结果一致。因此,LRP2基因敲除小鼠可作为研究病理性近视病因学的动物模型。
后巩膜葡萄肿是病理性近视的标志,也是发展为近视性黄斑病变的其他主要原因或后遗症之一[3,18,77,98,99,100]。后巩膜葡萄肿是最近更新的病理性近视定义的一部分,其特征是发生近视性脉络膜萎缩,等同于或严重于弥漫性脉络膜萎缩,或者存在后巩膜葡萄肿[3,4]。
正如Spaide[79]所描述的,后巩膜葡萄肿是围绕后极部眼底区域的一种隆起,其曲率半径比相邻的眼球壁的曲率半径小(图5)[4,5]。后巩膜葡萄肿应与简单的巩膜向后弯曲区分,因为简单的巩膜后弓在高度近视眼的OCT中很常见。


Moriyama等最近利用三维(three-dimensional,3D)-MRI分析了整个眼的形状[5,101,102],这样即使是较大的后巩膜葡萄肿也可以完全成像(图6)。基于眼的3D-MRI图像发现,眼球形状的不同与威胁视力的病理性近视发展有关[5]。Ohno-Matsui[102]最近应用3D-MRI和广域眼底成像将后巩膜葡萄肿分为6种类型:宽黄斑型、窄黄斑型、视盘旁型、鼻侧型、下方型和其他型(图7)。这种分类是基于Curtin[103]之前将葡萄肿分为的10种类型,其中Ⅰ~Ⅴ型是原发型葡萄肿,Ⅵ~Ⅹ型是复合型葡萄肿。最主要的葡萄肿类型是宽黄斑型(占葡萄肿的74%),其次是窄黄斑型葡萄肿(占葡萄肿的14%)。然而,把3D-MRI作为一种筛查手段并不可行,由于相对低的空间分辨率,浅层葡萄肿的细微变化难以被发现。




最近已经开发出一种新的广域扫频OCT系统的原型机,使用多条扫描线生成扫描图,允许对23 mm×20 mm大小感兴趣区域和5 mm深处进行后巩膜葡萄肿的三维重建。Shinohara等[104]发现,广域OCT可以提供迄今为止最大分辨率和范围的后巩膜葡萄肿的断层图像,并可能取代3D-MRI评估后巩膜葡萄肿。广域OCT显示葡萄肿边缘一致性的变化,表现为从视网膜周边到葡萄肿边缘脉络膜逐渐变薄,再从葡萄肿边缘向后极部逐渐增厚,并伴有葡萄肿边缘巩膜曲率半径的改变(图8)。


Tanaka等[105]研究了30例患者的55眼,平均年龄12.3岁,平均眼轴长度为27.9 mm,发现55眼中有7眼(占12.7%)巩膜后移而被诊断为葡萄肿。虽然葡萄肿通常被认为是在晚期发生的病理变化,但结果显示,后巩膜葡萄肿可以出现在比人们认为更早的时候。
超广域OCT被认为是鉴别儿童病理性近视的有效方法。其优势之一是可以看到神经视网膜的结构,并且可以检测葡萄肿和视网膜脉络膜并发症之间的关系。Shinohara等[106]发现,在葡萄肿眼中,近视黄斑区视网膜劈裂仅在葡萄肿区域内观察到。没有葡萄肿的眼近视黄斑区视网膜劈裂呈弥漫性。Takahashi等[107]分析了玻璃体粘连与葡萄肿的关系。
最后,我们热切期待出现针对葡萄肿的治疗方法。在危及视力的并发症发生之前,最理想的治疗方式是防治葡萄肿。
近视性黄斑病变,又称近视性黄斑变性,是病理性近视的重要特征。Curtin和Karlin[70]最先描述了5种与眼轴增长相关的近视性眼底改变,包括视盘萎缩弧、脉络膜视网膜萎缩、中央区色素紊乱、漆裂纹和后巩膜葡萄肿。后来,Avila等[108]研发了近视性黄斑病变的分级系统,其严重程度从0~5递增:M0为后极部外观正常;M1为脉络膜颜色变淡和豹纹状改变;M2为M1+后巩膜葡萄肿;M3为M2+漆裂纹;M4为M3+深层脉络膜萎缩病灶;M5为大面积的深层脉络膜视网膜萎缩,表现为"巩膜暴露"。在病理性近视的图集中[109],Tokoro更新和编辑了近视性黄斑病变的病变特征。Tokoro[109]根据检眼镜眼底检查结果将近视性黄斑病变分为4类:(1)豹纹状眼底;(2)弥漫性脉络膜萎缩;(3)局限性脉络膜萎缩;(4)黄斑出血。漆裂纹为弥漫性萎缩型,黄斑出血分为近视性MNV和单纯性黄斑出血2个亚型。随后,Hayashi等[98]对429例高度近视(近视性屈光不正>8 D或眼轴长度≥26.5 mm)患者806眼的自然病程进行了调查,随访5~32年。基于临床表现对Tokoro的分类进行了一些修订,将漆裂纹和近视性MNV归类为独立病变。这种对所有近视性黄斑病变损害的纵向观察为随后通用分类法(META-PM分类)的制定做出了巨大贡献[3]。
最近,一个国际近视研究小组回顾了既往的研究,并提出了一种简化的、统一的病理性近视分类系统(表2)。在这个简化的系统(META-PM分类法)中,近视性黄斑病变的损害分为5类,分别为无近视性视网膜病变(第0类)、仅豹纹状眼底改变(第1类)、弥漫性脉络膜视网膜萎缩(第2类)、局限性脉络膜视网膜萎缩(第3类)和黄斑萎缩(第4类)。在这个分类中增加了3个"附加体征":(1)漆裂纹;(2)近视性MNV;(3)Fuchs斑。将这些附加体征从分类中分开是因为这3种附加体征影响或潜在影响中心视力,可能由任何类别的近视性黄斑病变产生或共存。基于这种分类,病理性近视被定义为等于或大于第2类近视性黄斑病变,或存在附加体征、后巩膜葡萄肿。

META-PM分类和对视力的影响
META-PM分类和对视力的影响
| META-PM分类* | 视觉损害 | 病理性近视 |
|---|---|---|
| 分类 | ||
| 豹纹状眼底改变(1类) | 无 | - |
| 弥漫性脉络膜视网膜萎缩(2类) | 轻 | + |
| 局限性脉络膜视网膜萎缩(3类) | 中心凹旁暗点 | + |
| 黄斑萎缩(4类) | 中心暗点 | + |
| 附加体征 | ||
| 近视性黄斑新生血管(包括Fuchs斑) | 中心暗点,视物变形 | + |
| 漆裂纹 | 由于单纯出血导致颞侧暗点,视物变形(在一些病例中) | + |
*文献来源:Ohno-Matsui K,Kawasaki R,Jonas JB,et al.International photographic classification and grading system for myopic maculopathy.Am J Ophthalmol.2015;159∶877e883.
病理性近视定义为等同于或高于近视性黄斑病变分类第2类,或存在"附加体征",或存在后巩膜葡萄肿
豹纹状眼底的定义是由于眼轴增长导致脉络膜大血管可见性增加(图9)。豹纹状改变最先发展在视盘周围,特别是在视盘和中央凹之间的区域。与近视性黄斑病变的其他病变不同,单独的豹纹状眼底不影响中心视力(表2)。豹纹状眼底和近视弧是近视初期可见的征象之一,常见于高度近视儿童[110]。Wong等[111]也报道了在高度近视的中国青少年(12~16岁)中,最常见的是豹纹状眼底和视盘周围萎缩。


具有豹纹状眼底的高度近视患者明显比有近视性黄斑病变其他病变的患者年轻[21,77,98,112]。Xiao等[21]和Fang等[77]均指出,与第2类及以上的高度近视患者相比,有豹纹状眼底的高度近视患者,近视程度较低,眼轴长度较短。Tokoro[109]报告称,大约90%只有豹纹状眼底改变的眼眼轴长度<26 mm。有豹纹状眼底改变的比例随眼轴增长而呈线性减少,眼轴长度>31 mm的眼中没有豹纹状眼底改变。也就是说,几乎所有眼轴长度>31 mm的眼都会发展为晚期近视性黄斑病变(即弥漫性萎缩或局限性萎缩)。
高度近视眼底呈豹纹状改变的平均(或中位数)视网膜黄斑中央凹下脉络膜厚度为80~166 μm[7,112,113,114],与未发生近视性黄斑病变高度近视眼相比几乎减少一半[7,113]。豹纹状眼底脉络膜厚度分布模式不同于无黄斑病变的患者,但与较高等级的近视性黄斑病变类型(如弥漫性萎缩和局限性萎缩)相似。该发现提示,豹纹状眼底改变可能是近视变为病理性的首个标志。
Hayashi等[98]研究表明,在5~32年的随访后,有13.4%的豹纹状眼底改变出现了进展;10.1%发生弥漫性脉络膜视网膜萎缩,2.9%发生了漆裂纹,0.4%进展为MNV。在基于人群的北京眼科研究中,经过10年的随访,19%有豹纹状眼底改变的近视患者出现了进展[100]。另一组随访10年以上(平均随访18年)的810只高度近视眼的大规模研究显示出更高的进展率,为27%[77]。由于近视性黄斑病变分类级别越高的眼进展速度越快,提示近视性黄斑病变在豹纹状眼底阶段之后进展更迅速。豹纹状眼底可能是一种相对稳定的情况,高度近视眼可能在这种状态下维持较长的一段时间。
弥漫性脉络膜萎缩是出现在高度近视眼后极部眼底的一种边界不清的黄色病灶。病灶呈不均一黄色,颗粒状外观。然而,不同种族的眼底色素沉着程度不同,眼底颜色也可能不同。弥漫性脉络膜萎缩主要出现在视盘周围,并随着年龄的增长而增加,最终覆盖整个后极部[109]。因此,弥漫性脉络膜萎缩可分为乳头周围弥漫性脉络膜萎缩(peripapillary diffuse choroidal atrophy,PDCA)[30]和黄斑区弥漫性脉络膜萎缩(macular diffuse choroidal atrophy,MDCA)[77]2个亚型。弥漫性萎缩的发生率随年龄和眼轴长度的增长而增加[28,115]。Tokoro等[115]发现弥漫性萎缩通常发生在40岁左右,30%~40%的患者在40岁后出现。最近,Liu等[28]采用META-PM分类法,从年龄、眼轴长度和最佳矫正视力方面对弥漫性脉络膜萎缩的频率和分布进行评估。在中国的大规模高度近视人群中,7~11、12~18、19~39和40岁以上人群弥漫性脉络膜萎缩的比例分别为20.9%、9.2%、23.1%和52.9%。弥漫性脉络膜萎缩的发生率随着眼轴长度的增长而增加,眼轴长度<26.50 mm的患者发生率为3.6%,眼轴长度≥28.50 mm的患者发生率为62.8%。
荧光素血管造影(fluorescein angiography,FA)显示由于血管造影晚期组织染色所致的轻度强荧光[109]。在吲哚菁绿血管造影(indocyanine green angiography,ICGA)中,弥漫性萎缩区域的脉络膜毛细血管和中、大脉络膜血管明显减少。OCT显示弥漫性萎缩区域脉络膜明显变薄。临床观察发现,黄斑区弥漫性萎缩眼的中央凹下脉络膜厚度通常<100 μm,平均脉络膜厚度为50 μm[7]。在大多数病例中,脉络膜几乎消失,尽管偶尔残留大的脉络膜血管。也有较大的脉络膜血管凸出到视网膜。然而,即使在大部分脉络膜层缺失的区域,RPE层和外层视网膜依然存在。这可能解释了弥漫性萎缩眼相对保留了视力的原因。使用OCTA可以检测到脉络膜毛细血管血流障碍,尽管在病理性近视眼中可视化脉络膜循环仍然是一个挑战。弥漫性萎缩眼的OCTA显示存在中、大脉络膜血管,伴随低密度脉络膜毛细血管[111,116]。虽然呈豹纹状眼底改变的眼脉络膜变薄,但弥散性萎缩眼脉络膜变薄的程度要严重得多[7]。与周围组织(RPE、外层视网膜和巩膜)相比,脉络膜不成比例地变薄可能是弥漫性萎缩和病理性近视的关键特征。
局限性脉络膜萎缩是一种灰白色、界限清晰的萎缩[109]。由于RPE和大部分脉络膜的缺失,可以通过透明的视网膜组织观察到巩膜。局限性萎缩面积为0.03~101.3 mm2,平均1.73 mm2[117],直径<1个或多个脉络膜毛细血管小叶。在局限性萎缩区域内,特别是沿着萎缩的边缘或脉络膜大血管,可以观察到色素块[118]。在局限性萎缩的内部或边缘附近,通常可以观察到突然出现的血管,尤其是那些大的萎缩灶中[118]。临床上,日本的高度近视人群中10.5%的患者出现局限性萎缩[117]。局限性萎缩的百分比随年龄增长呈线性增加,60岁后达到32.5%[115]。眼轴长度为27.0~27.9 mm的眼局限性萎缩的患病率为3.3%,如果眼轴长度超过31 mm和32 mm,局限性萎缩的患病率分别超过25%和50%[115]。随着时间的推移,局限性萎缩扩大并相互合并[77,98,119]。
FA和ICGA显示在局限性萎缩区域脉络膜充盈缺损,提示此病变是由脉络膜毛细血管完全闭锁导致[109]。眼底自发荧光表现为边缘清晰的低自发荧光,这是由于局限性萎缩区域RPE缺失所致。局限性萎缩的OCT特征是RPE和外层视网膜的缺失,并丧失大部分脉络膜。因此,内层的视网膜直接与外层的巩膜表面接触。扫频OCT也显示局限性萎缩区的Bruch膜不连续[117,120]。RPE在黄斑Bruch膜缺损边缘外终止。局限性萎缩可以被认为是Bruch膜破裂,而不仅仅是萎缩。
局限性萎缩可分为由漆裂纹引起的局限性萎缩P(Lc)、在晚期弥漫性脉络膜萎缩区发生的局限性萎缩P(D)和沿后巩膜葡萄肿边缘可见的局限性萎缩3种亚型[98]。局限性萎缩的形状有助于区分这些类型,因为P(D)通常是圆形或椭圆形,而P(Lc)通常是沿径线发生的纵向椭圆形。P(Lc)被认为是由于漆裂纹导致的Bruch膜缺陷扩大,P(D)也可能代表在弥漫性萎缩晚期,这些区域内出现Bruch膜的孔洞[121]。
几乎所有局限性萎缩的眼(占95%)在平均随访18年后会发生进展,98%来源于原来的局限性萎缩扩大,47%是新出现的局限性萎缩,随后21.7%发展为近视性MNV,8.3%发展为局限性萎缩相关的黄斑萎缩[77]。Miere等[122]也报道,使用定量测量,所有的局限性萎缩在至少12个月内显著扩大。高比例的局限性萎缩的进展可以用Bruch膜的生物力学特性来解释:一旦缺陷产生,Bruch膜缺陷就会随着时间的推移,随着眼轴增长而扩大。然而,中央凹外局限性萎缩随后累及中央凹是罕见的。这意味着,虽然萎缩区域内光感受器的丧失可导致旁中心绝对暗点[123],但局限性萎缩引起中心视力丧失的情况也是罕见的(表3)。

使用抗VEGF治疗近视性脉络膜新生血管的三期临床试验总结
使用抗VEGF治疗近视性脉络膜新生血管的三期临床试验总结
| 研究 | 治疗组 | 例数 | 在研究主要终点的平均最佳矫正视力改变 | 在研究终点的平均最佳矫正视力改变 | 在研究期间注射抗VEGF的平均次数 |
|---|---|---|---|---|---|
| RADIANCE[158] | 以最佳矫正视力稳定为指导的0.5 mg雷珠单抗治疗 | 106 | 在3个月时提高10.5个字母 | 在12个月时提高13.8个字母 | 12个月治疗期间注射雷珠单抗4.6次 |
| 以疾病活动为指导的0.5 mg雷珠单抗治疗 | 116 | 在3个月时提高10.6个字母 | 在12个月时提高14.4个字母 | 12个月治疗期间注射雷珠单抗3.5次 | |
| 维泊芬光动力治疗3个月再加0.5 mg雷珠单抗治疗 | 55 | 在3个月时提高2.2个字母 | 在12个月时提高9.3个字母 | 3-12个月治疗期间注射雷珠单抗2.4次 | |
| BRILLANCE[160] | 以视力稳定为指导的0.5 mg雷珠单抗治疗 | 182 | 在3个月时提高9.5个字母 | 在12个月时提高12.0个字母 | 12个月治疗期间注射雷珠单抗4.6次 |
| 以疾病活动为指导的0.5 mg雷珠单抗治疗 | 184 | 在3个月时提高9.8个字母 | 在12个月时提高13.1个字母 | 12个月治疗期间注射雷珠单抗3.0次 | |
| 维泊芬光动力治疗3个月再加雷珠单抗治疗 | 91 | 在3个月时提高4.5个字母 | 在12个月时提高10.3个字母 | 3-12个月治疗期间注射雷珠单抗3.2次 | |
| MYRROR[161] | 2 mg阿柏西普治疗 | 91 | 在24周时提高12.1个字母 | 在48周时提高13.5个字母 | 48周治疗期间注射阿柏西普4.2次 |
| 假手术后24周再行2 mg阿柏西普治疗 | 31 | 在24周时下降2.0个字母 | 在48周时提高3.9个字母 | 24-48周治疗期间注射阿柏西普3.0次 | |
| SHINY[162] | 0.5 mg康柏西普治疗 | 132 | 在3个月时提高12.0个字母 | 在9个月时提高13.3个字母 | 9个月治疗期间注射康柏西普4.8次 |
| 假手术后3个月再行0.5 mg康柏西普治疗 | 44 | 在3个月时提高0.6个字母 | 在9个月时提高11.3个字母 | 3-9个月治疗期间注射康柏西普3.6次 |
注:VEGF:血管内皮生长因子
黄斑萎缩是以中央凹为中心,一种边界清楚、灰白色或白色的萎缩性病变。影像学特征与局限性脉络膜视网膜萎缩相似。局限性萎缩和黄斑萎缩的主要区别在于其位置相对接近中央凹。根据长期随访观察,黄斑萎缩可分为MNV相关的黄斑萎缩和局限性萎缩相关的黄斑萎缩。MNV相关的黄斑萎缩以中央凹为中心并向周围扩大,局限性萎缩相关的黄斑萎缩在中央凹区域以外发展并扩大,或与其他局限性萎缩合并进入中央凹[77]。这种划分方法主要是基于形态特征或MNV病史。大部分黄斑萎缩是MNV的萎缩阶段,少数与局限性萎缩扩大继发性累及中央凹有关。
在18年的随访中发现,最佳矫正视力的丧失与MNV的发生、MNV相关的黄斑萎缩以及MNV相关黄斑萎缩的扩大有关[77]。末次随访时,大多数最佳矫正视力<0.1(20/200)的眼都出现了黄斑萎缩。
在黄斑区内和周围可以观察到细的、不规则的黄色线状漆裂纹。漆裂纹被认为是RPE、Bruch膜和脉络膜毛细血管复合体的愈合和机械断裂[67,68]。多条漆裂纹常呈分枝状或交叉状。在多项队列研究中,高度近视眼漆裂纹的患病率为4.2%~15.7%[27,67,68,69,124]。在病理性近视患者中,漆裂纹可以在较早的年龄发生。Klein和Curtin[68]报道漆裂纹患者的年龄为14~52岁,平均32岁。之前的研究也表明,漆裂纹多发于眼轴长度为29.0~32.0 mm的眼[27,67,68,69,71,124,125,126,127]。
采用多模式成像技术可对漆裂纹进行诊断。ICGA被认为是检测漆裂纹的金标准,在晚期可观察到线性低荧光[126]。在FA上,漆裂纹在整个血管造影阶段显示一致的线性高荧光,早期阶段因RPE萎缩覆盖了Bruch膜的缺损出现窗样缺损,晚期阶段被染色的愈合瘢痕组织填充了Bruch膜的缺损。眼底自发荧光显示低荧光,这是由于萎缩的RPE覆盖在破裂区。在OCT上,由于漆裂纹太窄无法检测到,很容易被忽略。然而,当病变在OCT扫描范围内时,漆裂纹表现为RPE的不连续,并不断向RPE以外的深层组织辐射[71,127]。OCTA显示漆裂纹区域脉络膜毛细血管部分缺陷[116]。
Xu等[71]报道了53.7%的漆裂纹眼在平均3.5年的随访中发生了进展。有3种进展模式:数量增加(占43.9%)、伸长(占9.8%)和进展为局限性萎缩(占14.6%)。最常见的模式是漆裂纹数量增加。新的漆裂纹倾向于与现有漆裂纹垂直(分支)或平行分布。在一小部分眼中也可以看到现有漆裂纹的伸长和漆裂纹的宽度增加,并发展为局限性萎缩。在一些眼中,这种进展并不是已存在漆裂纹的均匀扩大,而是小的圆形局限性萎缩区域首先沿着漆裂纹的线条发展,然后这些圆形区域扩大并相互融合。
虽然漆裂纹经常在MNV附近出现[108],但从现有的漆裂纹中继发MNV是不常见的。这一发现表明被视为漆裂纹的黄色线状病变代表了愈合的瘢痕组织。当漆裂纹新形成时,MNV可能通过Bruch膜破裂而发生。然而,一旦Bruch膜破裂被瘢痕组织修复,继发性MNV很少发生。
漆裂纹在中央凹形成是罕见的。因此,漆裂纹本身一般不会损害中心视力;然而,Bruch膜破裂时发生的视网膜下出血,即使在出血吸收后也可能导致中心视力受损(表2)。
MNV是病理性近视中心视力受损的主要原因,其已作为附加体征包含在META-PM分类中。MNV分为3个阶段:以MNV、渗出和出血在内的纤维血管膜增生为表现的活跃期;以Fuchs斑为表现的瘢痕期;以MNV相关性黄斑萎缩为代表的萎缩期。因此,Fuchs斑不被认为是独立的病变,其是MNV瘢痕期的表现。更多的细节将在"近视性MNV"一节中讨论。
由于META-PM分类很适合于识别不同阶段的近视性黄斑病变,这种分类只需检查眼底照片,而不同种族眼底色素沉着程度有不同的外观表现,所以只能准确诊断萎缩性病变。此外,其他的近视性黄斑病变,如近视牵引性黄斑病变和圆顶状黄斑不包括在内。因此,研发出了一个基于OCT的分类系统[7]。更进一步的细节将在基于OCT的近视性黄斑病变的分类章节中讨论。
最近,Ruiz-Medrano等[128]总结了病理性近视的主要特征,并提出了一种基于萎缩、牵引和新生血管3个关键因素的新分类系统,即ATN分类系统。该分类系统没有对当前的萎缩分类(META-PM分类中的5个分类)进行更改。牵引性组分包括5个阶段:内层或/和外层中央凹劈裂、中央凹脱离、黄斑裂孔和视网膜脱离。META-PM分类中的3个附加体征则被认为是新生血管组分。
Fang等[77]在META-PM分类的基础上,对432例高度近视患者的810眼进行了10年以上随访的回顾性系列病例研究,结果显示平均随访18年后58.6%的眼观察到近视性黄斑病变的进展,其中74.3%开始纳入研究时即患有病理性近视。最常见的3种进展模式是:(1)弥漫性萎缩中,视盘周围弥漫性萎缩扩展到黄斑弥漫性萎缩;(2)局限性萎缩中,原有的萎缩病变扩大;(3)漆裂纹中,出现局限性萎缩。在2项基于中国人群的纵向研究中,中国老年人(≥40岁)(北京眼科研究)[100]的近视性黄斑病变10年进展率为35.5%,中国农村成年人(≥30岁)(邯郸眼科研究)的近视性黄斑病变5年进展率为35.3%[129]。在另一项中国大规模高度近视的队列研究(中山眼科中心-Brien Holden视力研究所合作的高度近视队列研究)中,高度近视657眼中约15%在2年内发生了近视性黄斑病变进展[130]。年龄大、眼轴长、存在后巩膜葡萄肿是近视性黄斑病变发生和发展的主要因素。


第一,从0类(无近视性黄斑病变)进展到1类(豹纹状眼底改变)与视力下降无关。虽然豹纹状眼底改变不认为是病理性近视,但脉络膜显著变薄始于豹纹状眼底改变的出现,这是近视性黄斑病变进展的第1个迹象。第二,弥漫性萎缩(第2类)主要发生在视盘周围区(PDCA),并最终扩展到黄斑(MDCA)。第三,局限性萎缩眼球的黄斑区Bruch膜上有一孔洞,要么是由漆裂纹扩大形成的,要么是在弥漫性萎缩发展到晚期的更脆弱的Bruch膜区域形成的。第四,局限性萎缩和黄斑萎缩(MNV相关和局限性萎缩相关)均随时间推移而扩大。第五,黄斑萎缩几乎总是与MNV相关,尽管局限性相关的黄斑萎缩偶尔也会发生。
采用先进的多模式成像技术明确了近视性黄斑病变的病变特征。广泛使用的META-PM分类系统允许研究人员在研究中进行直接比较,并为临床试验和流行病学研究提供了常用的工具。针对近视性黄斑病变发病机制的进一步研究将有利于找到有效的治疗方法,最终阻止近视性黄斑病变的进展。
目前近视性MNV的发病机制尚未完全阐明,已经提出了一些理论,如机械论和遗传性退行性变论来解释近视性MNV的发展[108,131,132,133]。病理性近视的背景改变被认为是近视性MNV发病机制的原因。这些结构变化涉及到眼的多个层次,包括RPE、Bruch膜、脉络膜毛细血管层、脉络膜和巩膜,主要由眼轴增长驱动。随着近视性黄斑病变严重程度的增加,临床上可以观察到这些变化。与近视性MNV相关的特异性病变包括漆裂纹、局限性萎缩和大的近视弧。脉络膜的显著变薄和脉络膜大血管的丧失表明,脉络膜的灌注受损可能加重近视性黄斑病变进行性萎缩的发展[134,135,136]。在许多近视性MNV眼中都有漆裂纹,被认为是重要的诱因病变[69]。漆裂纹代表了Bruch膜断裂,因此,机械拉伸被认为是潜在的危险因素[137]。也有研究揭示了细胞因子在病理性近视中的改变,因为其可能参与了近视性MNV的发病机制[138]。在近视性MNV患者中,与做过白内障手术的眼相比,房水中VEGF水平增高[139]。也有研究表明,基因或遗传因素可能在近视性MNV的发展中起作用[48]。补体因子I基因中的单核苷酸多态性与近视性MNV有关[48]。
近视性MNV的诊断主要基于临床表现。患者可出现视物模糊、盲点或视物变形。检眼镜检查时,常常可以观察到病理性近视的特征表现,如弥漫性或局限性脉络膜萎缩或近视弧[69,140]。近视性MNV典型表现为位于视网膜中央凹下方(或临近视网膜中央凹)的脂样、小的、灰色的视网膜下病变,伴或不伴有出血[4,108,131,132,133]。SD-OCT是一种有用的筛查工具,因为其无创且检查迅速。在SD-OCT上,近视性MNV表现为RPE上方相邻的高反射区(2型MNV),通常伴有少量视网膜下液(subretinal fluid,SRF)。
临床上通常由FA确诊近视性MNV,其能显示新生血管的存在,在典型的MNV中,早期表现为界限清晰的高荧光,晚期出现渗漏。最近,OCTA也因具有高灵敏度和特异性而用于无创检查近视性MNV[141,142,143]。OCTA的主要优势在于其非侵入性,可在每次就诊时进行重复扫描。因此,一些眼科中心现已接受任何一种形式的血管造影来诊断近视性MNV。然而,由于OCTA是一种相对较新的技术,检查者需认识到其局限性,包括各种伪影和分割错误[144]。OCTA很大的局限是不能仅根据OCTA来可靠地评估新生血管是否处于活动期。因此,建议结合结构OCT来解读OCTA,以全面评估MNV的存在、类型、区域和活动性。
对MNV活动的准确评估对于决定何时开始治疗以及是否不再需要进一步治疗非常重要。FA渗漏的证据是评估MNV活动性的金标准[133]。然而,由于FA具有侵入性,不能频繁重复检查。SD-OCT已经逐渐取代FA成为评估MNV活动的主要方式,特别是在随访期间。在活动期,近视性MNV典型表现为RPE上方呈圆顶状、高反射性、边界不清的高反射凸起[145]。此外,缺乏RPE覆盖也可以帮助区分活跃的MNV和不活跃的或瘢痕性的MNV[146]。SD-OCT在评估合并近视牵拉性黄斑病变时非常有用,而抗VEGF治疗可能会加重MNV[147]。虽然OCTA可以检测出新生血管区域,但不能反映新生血管的活动水平。MNV内的血流信号通常持续在近视性MNV的瘢痕期或萎缩期。
近视性MNV的鉴别诊断包括高度近视眼的单纯性黄斑出血,这通常与漆裂纹有关。单纯性黄斑出血FA仅表现为遮蔽荧光,OCTA无强血流信号,SD-OCT表现为沿Henle纤维层的放射性出血[148]。ICGA的后期也有助于确认MNV的缺失,并用于检测并发的漆裂纹的线性低荧光。一些炎症疾病可表现为与近视性MNV相混淆的体征,最常见的疾病是急性多灶性脉络膜炎和全葡萄膜炎,以及点状内层脉络膜病变伴或不伴继发性MNV[4,133]。在50岁以上的近视患者中,新生血管性AMD可能与近视性MNV混淆。息肉样病变可发生在葡萄肿边缘或杯盘倾斜综合征的眼。特发性MNV是通过排除其他诊断而成立的;也就是说,这是一种排除性的诊断。最后,伴或不伴有新生血管的浆液性脱离也可发生在圆顶状黄斑病变的眼中。
未经治疗的近视性MNV的自然病程通常不佳[149,150,151]。评估未经治疗的近视性MNV长期视力结果的10年随访研究发现,在10年时视力显著下降,视力为20/200或更低的比例从开始时的29.6%增长到5年时的88.9%和10年时的96.3%[150]。因此,为了防止进行性视力丧失,治疗近视性MNV是必要的。
在维泊芬光动力治疗(verteporfin photodynamic therapy,vPDT)研究中[152],vPDT成为第1个被批准的治疗近视性MNV的方法,vPDT治疗眼比假手术治疗眼有更好的平均最佳矫正视力。然而,vPDT并不能使2年后的平均视力提高[152]。此外,与玻璃体内注射抗VEGF药物治疗相比,vPDT还更容易出现脉络膜视网膜萎缩,且视力更差[153]。因此,在抗VEGF治疗的时代,近视性MNV的标准治疗是使用玻璃体内注射抗VEGF药物治疗,而不推荐vPDT[133,154,155,156,157]。
玻璃体内注射抗VEGF药物治疗近视性MNV的有效性和安全性已在大量的大规模、Ⅲ期、多中心、随机对照临床试验中进行了评估,包括RADIANCE[158,159]、BRILLIANCE[160]、MYRROR[161]和SHINY(表3)[162,163]。RADIANCE和BRILLIANCE研究评估了玻璃体内注射0.5 mg雷珠单抗和vPDT的有效性和安全性[158,159,160],而MYRROR和SHINY研究分别比较了玻璃体内注射2 mg阿柏西普和注射0.5 mg康柏西普与假手术治疗[161,162]。这些随机对照试验的结果均证实,玻璃体内注射雷珠单抗、阿柏西普和康柏西普治疗近视性MNV在主要的治疗终点可显著提高患者的平均视力,且具有良好的安全性。这些积极的发现使各国卫生当局都批准使用这些抗VEGF药物用于治疗近视性MNV。贝伐单抗和阿柏西普最初用于治疗系统性肿瘤,但也被用于玻璃体内注射治疗近视性MNV,2种药物治疗后都能获得良好的视力[164,165,166,167]。然而,使用玻璃体内注射贝伐单抗或阿柏西普治疗近视性MNV缺乏强有力的临床试验数据。因此,使用这些抗VEGF药物治疗近视性MNV应仅限于无法获得抗VEGF处方药的患者。
与抗VEGF药物治疗新生血管性AMD所致的MNV相比,使用抗VEGF治疗近视性MNV的治疗负担明显较小。玻璃体内注射抗VEGF药物治疗近视性MNV的推荐治疗方案是首次单独注射,然后根据需要注射,定期使用SD-OCT监测疾病活动[155,156]。该方案依据RADIANCE和BRILLIANCE研究中使用雷珠单抗的疾病活动的指导意见和MYRROR研究中使用阿柏西普的治疗方案[161]。在各项已实施的研究中,已对这种按需治疗方法的有效性进行了评估[168,169]。前瞻性的LUMINOUS研究展示了在实际治疗中,雷珠单抗治疗近视性MNV 1年后,可使患者的平均视力提高,开始治疗的患者提高9.7个字母,之前已治疗过的患者提高1.5个字母,且在12个月内只接受很少的平均注射次数,分别是3.0次和2.6次[168]。另一项在日本评估雷珠单抗治疗近视性MNV的大规模前瞻性真实世界研究中也显示了类似的结果,在LogMAR视力表中最佳矫正视力平均提高0.19单位,12个月内平均注射2次,是较低的注射频次[169]。RADIANCE研究的长期结果也证实了良好的视力结果和较少的再治疗次数,平均视力增加了16.3个字母,83%的患者在长达48个月的随访后不再需要进一步治疗近视性MNV[170]。
一些研究已评估了在使用抗VEGF治疗近视性MNV中与各种治疗结果相关的预后因素[159,171,172]。RADIANCE研究中一项亚组分析显示,无论基线年龄、种族、病变区域、MNV位置、近视严重程度、眼轴长度以及是否存在SRF,雷珠单抗治疗均可显著提高视力[159]。在研究期间发现,与MNV病变面积较小的眼相比,原本病变较大的区域需要更多的注射次数[159]。MYRROR研究中的post hoc分析也显示,在玻璃体内注射阿柏西普治疗近视性MNV后,近视性黄斑变性的严重程度似乎并不影响视力或解剖结构[171]。另一项研究表明,雷珠单抗或贝伐单抗治疗后更好的视力结果可能与症状持续时间较短、较好的基线最佳矫正视力和眼底自发荧光模式有关[172]。
关于抗VEGF治疗近视性MNV后的长期视力预后的主要问题之一是发生与MNV相关的近视性黄斑萎缩,这可能导致早期长时间治疗所获得的视力逐渐丧失[157,165]。由于目前近视性MNV的抗VEGF治疗仅针对血管生成过程,因此,未来的研究工作应关注治疗近视性MNV相关的黄斑萎缩的方法,以获得更好的长期视觉效果。
近视牵引性黄斑病变在高度近视眼中有多种继发于视网膜牵引力的病变,包括视网膜前膜、板层裂孔和其他对视网膜产生牵引力的疾病。在近视牵引性黄斑病变中,近视性黄斑劈裂是病理性近视所特有的,作为一种特殊的并发症值得关注。由于篇幅的限制,本文只粗略阐述这种病理过程。Phillips于1958年首次报道在高度近视眼中,近视性黄斑劈裂是指后极部视网膜脱离而无黄斑裂孔[173]。近40年后,Takano和Kishi[174]发现高度近视患者视网膜劈裂和中央凹视网膜脱离在OCT中很常见。近视性黄斑劈裂以各种中央凹结构异常为特征,包括中央凹囊样改变、板层裂孔和中央凹视网膜脱离[175]。
典型的OCT图像显示后巩膜葡萄肿内的视网膜内层和外层分裂,据此猜测,视网膜内层比外层柔韧性差[176]。限制视网膜内层柔韧性的因素包括玻璃体皮质黏附于视网膜上、视网膜前膜、内界膜和视网膜血管。视网膜前膜在高度近视中通常很难识别,但显微镜下可分辨[177]。任何一种或所有的这些因素都会降低视网膜的柔韧性。
由黄斑裂孔引起的视网膜脱离是高度近视眼的典型并发症。在高度近视眼中,玻璃体皮质紧贴裂孔周围视网膜表面,产生切向牵引力,在葡萄肿的深部产生向内的向量分量,导致视网膜脱离[178]。
(1)症状 患者通常能感受到中央视物变形,这与视网膜劈裂位置和视网膜脱离导致的相对暗点对应。当视网膜脱离区内的黄斑裂孔裂开时,患者可能在相对暗点中心感觉到有1个绝对暗点。如果伴有广泛的视网膜脱离,患者也会感觉到受累区域的视野缺失。对于视网膜脱离区域内的黄斑裂孔,Watzke-Allen试验通常呈阴性。(2)眼底及OCT表现 在高度近视眼中,近视黄斑裂孔表现为后部视网膜的轻微隆起;然而,OCT对于准确诊断是必不可少的,特别是在萎缩的眼底。OCT不仅对全面评估视网膜的状态至关重要,而且对手术决策也至关重要。近视黄斑裂孔表现为多个层次的视网膜劈裂(图11)。在分裂的视网膜各层之间通常有一些连接物,即所谓的柱,推测这是残存的Müller细胞[179]。内界膜也可以与其他视网膜层分离,即所谓的内界膜脱离(图12A),这是来自视网膜内界膜牵引力的良好指标[180]。OCT图像上可以看到视网膜内层的帐篷状凸起。这一发现与视网膜血管和所谓的视网膜微血管牵引相一致,在玻璃体切割联合内界膜剥除手术后观察得更清晰(图12B)[181]。这种对视网膜血管的牵引力在高度近视眼中也可作为血管旁微孔被观察到[182]。光感受器的椭圆体带有时在视网膜脱离区也会消失[183];然而,椭圆体带在视网膜劈裂区通常保存完好。这一发现表明,光感受器的功能在这种亚型中保存良好。




根据OCT表现,黄斑裂孔形成前有2个阶段与视网膜劈裂相关(图13)。第1个阶段是视网膜劈裂型的发展阶段,在这个阶段中只有视网膜劈裂而没有视网膜脱离(图13A)[176]。几个月(有时几年)后,中央凹附近开始出现视网膜脱离。这一阶段称为中央凹脱离型(图13B)。一段时间后,脱离上方的内层视网膜被拉伸和撕裂。这就是视网膜劈裂伴视网膜脱离导致黄斑裂孔的原因。


高度近视有2种类型的黄斑裂孔(图14)[184]。一种类型是裂孔边缘增厚并伴有视网膜囊样改变(图14A)。临床上裂孔周围无视网膜脱离,这种类型通常数月或数年不发生变化。另一种类型是在裂孔周围环绕着视网膜劈裂,而不是视网膜囊样改变(图14B)。这种类型的黄斑裂孔是由近视性黄斑劈裂引起的,通常由于潜在的牵引力而进展迅速。


研究显示,69%的患者视力下降,31%的患者在3年随访后出现黄斑裂孔[185],50%的视网膜劈裂患者在2年后出现黄斑裂孔或视网膜脱离[186]。这些观察结果支持对近视性黄斑劈裂进行手术,以防止更严重的疾病,即黄斑裂孔。
无症状的近视性黄斑劈裂不是好的手术适应证,因为有相当数量的患者术后视力下降。中央凹视网膜脱离的患者术后视力改善的可能性要比单纯视网膜劈裂大得多[187,188]。如果术前有黄斑裂孔,视力改善的机会明显变小[187]。
黄斑裂孔合并视网膜脱离的患者玻璃体切割术后平均视力<20/200,首次玻璃体切割术后复位率为50%~70%[189]。一旦黄斑裂孔发展,玻璃体切割术后这些高度近视眼的裂孔就很难愈合[190]。OCT图像显示视网膜劈裂或视网膜脱离的黄斑裂孔封闭率为40%~50%[191]。裂孔闭合困难可能是由于后巩膜葡萄肿的存在导致视网膜极度的拉伸。事实上,较长的眼轴通常是1个较差的预后因素[192]。
由于玻璃体起着重要作用,因此使玻璃体后脱离至关重要。为了使玻璃体后脱离,通常使用玻璃体切割器和带主动抽吸的硅尖端反冲洗针。由于玻璃体皮质、视网膜前膜和内界膜等多种成分紧密附着在视网膜表面[193],金刚石涂层刮膜器有助于剥离这些极薄的膜。要注意的是,由于有形成黄斑裂孔的风险,在分离黄斑处的玻璃体时需要非常小心。
对近视性黄斑劈裂是否要剥除内界膜仍有争议。然而,在大多数眼的OCT图像上,内界膜与其他视网膜层是分离的[180],表明内界膜的韧性起着重要作用。对于近视性黄斑裂孔伴有视网膜脱离的患者,内界膜剥离还可以促进黄斑裂孔的闭合,消除所有对视网膜的牵引力,提高成功率[194]。吲哚菁绿或亮蓝G常用于内界膜染色。
据推测,内界膜剥离引起的中央凹机械损伤可能导致近视性黄斑劈裂的中央凹全层组织丢失。这个观念使眼科医生不敢触碰中央凹的内界膜。最近,引入了一种非中央凹内界膜剥离技术以避免黄斑裂孔形成[195]。到目前为止,术后黄斑裂孔的发生率显著降低;然而,即使有较高的解剖复位率,但视力仍无提高[196]。
高度近视眼的黄斑裂孔不太可能闭合。内界膜翻转术被用于高度近视患者,但视力是否提高尚未得到证实,特别是在视网膜脱离的病例中;然而,黄斑裂孔闭合率似乎高于传统的内界膜剥除术[197]。一项使用内界膜翻转术的研究表明,其黄斑裂孔闭合率显著高于传统的内界膜剥除术[198]。最近有报道称,自体内界膜[199]或板层视网膜或全层视网膜移植[200,201]可提高近视性黄斑裂孔的闭合率。
由于黄斑周围没有凝血机制,因此长期支持视网膜对于恢复RPE和光感受器之间的完整性至关重要。最好使用长效气体填充(即全氟丙烷)以获得更大的解剖成功率[202]。硅油填充也被认为是一种有效的选择[203]。
在接受玻璃体切割治疗的近视性黄斑劈裂患者中,有10%~20%出现了黄斑裂孔[187]。对视网膜极薄、存在中央凹牵拉的病例进行内界膜剥离有出现这种并发症的风险。有研究观察了术后黄斑裂孔形成的发生率,并寻找了危险因素[204]。术前OCT上看到的椭圆体带不连续缺损是黄斑裂孔发生的预测因素。其他因素,如年龄、性别和视力,不影响黄斑裂孔的形成率。
视网膜脱离复发是黄斑裂孔合并视网膜脱离患者进行玻璃体切割术后的主要并发症。在再次手术时,去除残留的玻璃体皮质和视网膜前膜至关重要。然而,有时很难确定视网膜再次脱离的明显原因。在这些病例中,持续的牵引,如微血管牵引可能是原因所在。这些病例可以考虑黄斑顶压。对于伴有视网膜脱离的黄斑裂孔患者,黄斑顶压可以抵消所有的牵引力,首次复位率略高于玻璃体切割术[205,206]。
随着眼科成像技术的进步,人们对近视性黄斑病变的病理生理学有了更深入的了解。许多有趣的发现表明,高度近视眼中存在潜在的牵引力。这些病理状态的特征术前应该被仔细评估,因为这些特征对于决定是否手术及评估有近视性黄斑并发症患者更有效的手术方式很重要。
2008年,1个法国研究小组报告了1种之前未被描述的导致近视患者视力丧失的原因,称其为圆顶状黄斑[207],以后极部脉络膜视网膜的凹面内出现黄斑向内隆起为特征。在眼底生物显微镜下很难发现黄斑隆起,主要在OCT可见。他们报告了5例单侧和5例双侧的病例,对应于其数据库140眼近视眼中的15眼,屈光度为-2~-15 D。11眼视力下降,中位视力为20/50。研究还发现所有眼均有不同程度的RPE改变,包括RPE萎缩和色素沉积。7眼发现局灶性荧光素渗漏,但所有病例均可排除MNV[207]。这一发现得到了来自不同国家研究者的证实,可以更好地描述这种疾病。据估计,中国近视人群中圆顶状黄斑的患病率为10.7%~14.6%[208,209]。大多数报告的病例是成人患者,但儿童和青少年也有报道[210]。圆顶状黄斑通常存在于轻度至中度近视的患者,但这种情况也可发生在高度近视、正视眼和极少数的远视眼中[211,212]。根据圆顶的形状,圆顶状黄斑的亚型可分为圆形(图15)、垂直轴椭圆形(图16)或水平轴椭圆形(图17,图18)[213,214,215]。在这些研究中,水平轴圆顶状黄斑占了2/3~3/4病例。因此,建议在不同的轴线上进行OCT矢状面和横断面扫描,以诊断圆顶状黄斑。








在最初描述时使用的是时域OCT,但无法证明隆起是否来源于巩膜[207,212]。OCT显示,与无圆顶状黄斑的近视眼相比,伴有圆顶状黄斑的近视眼黄斑区巩膜明显增厚[216],而黄斑区以外的巩膜厚度并无差异。因此认为,在高度近视患者中,圆顶状黄斑可能是黄斑下巩膜厚度相对局部改变的结果。在另一项研究中发现,圆顶状黄斑与后巩膜葡萄肿2个外凹之间的脊相对应[217]。最近,3D-MRI可以重建这些眼的整个后极部,并发现整个后极部存在的形态学改变,形成向内凸起的条带,这个条带从视盘延伸到中央凹,在大多数眼内形成水平轴椭圆形圆顶状黄斑;黄斑区形成圆形向内的凸起时,在大多数眼内形成圆形圆顶状黄斑。这项MRI研究也显示了这些凸起的极度多样性,这可能是单个或多个葡萄肿区域的边缘形成的[209]。脉络膜厚度的研究结果更具争议性。有研究报道脉络膜较厚[211,212],也有研究报道脉络膜较薄[218]。有一项比较研究认为,在眼轴长度相同时,有或没有圆顶状黄斑的眼脉络膜厚度是相同的[219]。然而,平均中央脉络膜厚度似乎比围绕葡萄肿的脉络膜厚,并且其与平均黄斑旁脉络膜厚度的比值似乎在圆顶状黄斑中更大,而在其他眼轴长度相同的近视患者中,比值较小[220]。因此,圆顶状黄斑可能与隆起边缘较厚的巩膜和脉络膜相关。
对49岁女性轻度近视性屈光参差患者双眼进行比较,提出圆顶状黄斑可能是近视性屈光参差的代偿机制[221]。然而,目前对这种疾病的发生所知甚少,这种情况可能是单侧的,也可能是双侧的。Ohno-Matsui等[222]观察到圆顶状结构的周围脉络膜增厚。基于这一发现,他们推测,在圆顶状黄斑顶点可能存在一种圆顶诱导Bruch膜向内推的力,导致中央凹下的脉络膜受压。他们还观察到20%的眼有Bruch膜缺陷,这表明在圆顶状结构的斜坡上存在Bruch膜张力[222]。
长期的研究表明,随着时间推移,圆顶状黄斑隆起的高度会适度增加[218,219],增加的高度与黄斑萎缩性病灶扩大有关[219];且中央凹和旁中央凹区域的巩膜厚度略变薄[218]。
圆顶状黄斑的主要并发症为黄斑区浆液性视网膜脱离(serous retinal detachment,SRD)。在所有研究中均观察到黄斑区SRD,但其发病率各异,从日本队列研究中的1.8%到法国累积研究中的54%[214,220]。圆顶状黄斑被认为是一种威胁视力的疾病,导致大多数患者视力丧失。当隆起高度大于350 μm时,有垂直轴椭圆形圆顶状黄斑的眼中更容易观察到SRD[213,223]。SRD的发病机制尚不清楚,但最近有研究表明,OCTA垂直和水平扫描测量的有SRF的黄斑下脉络膜血流比没有SRF的眼更大[220]。因此,不同研究团队观察到的在隆起和葡萄肿过渡区域的脉络膜厚度变化[217,224]可能与脉络膜血流的突然改变相对应,导致血-视网膜外屏障破坏引发SRF。SRF的自然病程特征是其高度发生重大变化,有时可能导致液体完全消退[225]。液体消退也可能与RPE和黄斑区外层视网膜萎缩的发展相对应[219]。大多数与圆顶状黄斑相关的SRF的研究表明,基线或随访期间患者的视力较差[219,226],但在一项研究中发现,随访2年后,伴有或不伴有SRF的眼预后相似[227]。
其他报道的并发症包括圆顶顶端的色素上皮脱离[228]、息肉状脉络膜血管病变[229]以及在OCTA上更容易观察到的MNV[228,230]。一项系列比较研究[231]和RADIANCE试验[232]报道了有或没有圆顶状黄斑的眼中MNV对雷珠单抗类似的反应。
圆顶状黄斑及其并发症与视盘倾斜综合征眼中常见的下方葡萄肿非常相似。事实上,这2种疾病都包含眼球曲率的改变[233],可能会导致色素改变、MNV、息肉状脉络膜血管病变和SRF等并发症发生[234,235,236]。不同研究都强调了这些疾病之间的相似性[237,238,239],并提出了类似的假说来解释SRF的发生[240]。最近,有一种接近圆顶状黄斑的疾病,称为脊样黄斑,在较年轻的患者(<20岁)中被发现。脊样黄斑的特征是在OCT垂直扫描的水平方向上,观察到只有一条越过中央凹的经线上出现水平的黄斑区抬高。在这个研究中,未发现葡萄肿和Bruch膜缺损[241]。
目前尚缺少治疗圆顶状黄斑的有效方法。MNV或息肉状脉络膜血管病变等并发症应及时使用抗VEGF药物治疗。对并发于圆顶状黄斑的SRF已经提出了不同的治疗方法,包括光动力治疗[242,243]、螺内酯[244]、阿柏西普[245]和局部碳酸酐酶抑制剂[246]。圆顶状黄斑并发SRD在视网膜前膜剥除手术后观察到短暂的改善[247]。但目前的研究均为病例报告或小规模系列研究,缺少对照组。到目前为止,尚缺少治疗并发于圆顶状黄斑的SRF的有效方法。
META-PM研究小组对病理性近视的定义是高度近视眼的黄斑区形态异常,而忽略了同时存在的视盘改变[3]。然而,在病理性近视眼中,视神经损伤往往与黄斑病变并存,且并不少见,这是视野缺损和视力损害的另一原因[248,249,250]。在基于不同种族的人群研究中,青光眼或青光眼样视神经病变患病率的增加发生在近视性屈光不正超过-8 D或眼轴长度超过26.5 mm的眼中[248,250]。这表明,低度至中度近视或眼轴长度小于26.5 mm的青光眼患病率与正视眼相似。当视盘和视盘旁区域的扩大作为高度近视存在的生物学标志物时,-8 D的屈光不正或26.5 mm的眼轴长度是定义高度近视的临界值[251,252]。
视盘的外观对于诊断和更好地理解近视性青光眼非常重要。视盘的改变可分为非高度近视和高度近视2种。在高度近视中,与眼轴增长相关的主要变化是Bruch膜开口与筛板空间关系上的移位,通常向黄斑方向移位[253]。视盘由3层组成,Bruch膜开口为内层,脉络膜开口为中间层,视盘周围巩膜边缘和筛板开口为外层,Bruch膜开口向颞侧方向移位,导致Bruch膜覆盖超过鼻侧视盘边缘到达视盘内部的区域,而颞侧视盘旁区域Bruch膜缺失。这解释了视盘旁γ区的发生,通常位于颞侧到颞下视盘旁区域,这是由Bruch膜缺失导致的[254,255,256,257,258]。一个解释Bruch膜开口向黄斑方向后退的假说认为在眼轴增长的正视化和近视化的过程中,赤道区域产生了新的Bruch膜[93]。作为Bruch膜开口移位(通常发生在水平面上)的后果,通过检眼镜检查,视盘形状从几乎正圆变为垂直的椭圆形。检眼镜下发现垂直视盘形状的另一个解释是由于视盘倾斜,眼底镜下的视盘图像发生了透视畸变[259]。在非高度近视眼中,视盘的大小与屈光不正的眼轴长度无显著相关性[260]。相应地,非高度近视眼的Bruch膜开口的大小与眼轴长度无关[253]。
在高度近视中,Bruch膜开口和视盘(定义为以筛板为底部的区域)的大小以及随后筛板的大小均随眼轴伸长而增加[253,260]。Bruch膜开口的增大导致环形γ区的发展,即Bruch膜开口的增大比视盘(及筛板)的增大更明显。随着视盘和筛板的增大,筛板拉伸变薄。筛板变薄缩短了存在眼内压力的眼内腔室与存在眼眶脑脊液压力的球后腔室之间的距离[261,262]。这2种压力形成了筛板压差,对青光眼视神经病变非常重要[263,264]。2个腔室之间的距离减小导致跨筛板的压力梯度变大,这可能是高度近视患者青光眼易感性增加的原因之一[248,249,250]。青光眼易感性增加的另一原因可能是与筛板内部拉伸相关的形态学改变。
在视盘旁区,高度近视眼除了γ区外,还有视盘旁Δ区的发展和扩大[258]。Δ区相当于拉长(拉伸)和变薄的视盘旁巩膜边缘(在γ区内)[265],其为后部巩膜内层进入筛板的延续,是在巩膜边缘与筛板间纵横交错的视盘旁巩膜边缘组织的胶原纤维[266]。视盘旁的巩膜边缘形成眶脑脊液腔的前缘,仅被视盘周围的视网膜神经纤维层覆盖[265],它形成了筛板的生物力学锚点[267]。后巩膜外部与视神经硬脑膜融合,环状Zinn-Haller动脉环常位于融合线上[265]。动脉环大致可作为检眼镜下Δ区的外围分界线。因此,与眼轴增长相关的视盘旁巩膜边缘的伸长导致动脉环与筛板之间的距离增加,而筛板是由动脉环的分支滋养的。动脉环与筛板之间的距离增加可能是高度近视眼视盘易损程度进一步增加的原因[248,249,250]。与视盘旁巩膜边缘作为筛板生物力学锚点的作用相吻合,一项临床研究表明,高度近视较大的Δ区与较高的青光眼视神经病变患病率相关[249]。同样,较大的视盘与较高的青光眼易感性相关,而γ区的大小与青光眼的患病率无关[249]。
视盘旁边缘组织在视盘生物力学和青光眼易感性方面的重要性至今仍不明确。视盘旁边缘组织分化为视盘旁巩膜缘组织和视盘旁脉络膜组织[266]。第1个与视神经软脑膜相延续,当巩膜边缘过渡到筛板时,其与巩膜边缘的纤维交织。第2个位于视盘旁巩膜缘组织与Bruch膜末端之间,其形成了脉络膜腔和视盘内部筛板前腔室之间的边界[266]。眼球内壁(也就是葡萄膜、Bruch膜和视网膜)与眼球外壁(也就是巩膜)仅与前面的巩膜突和后面的穿过视盘旁脉络膜边缘组织直接或间接地相连接。一般来说,视盘旁脉络膜边缘组织对整个眼球可能更具有生物力学意义,特别是承载眼压的眼内壁和筛板之间的连接处。由于γ区的发展,Bruch膜的末端与可见的视盘边缘之间的距离拉长[266],导致视盘旁脉络膜边缘组织变薄。在一些高度近视眼中,脉络膜边缘组织可能破裂,导致Bruch膜末端游离,并在其附近区域形成Bruch膜皱褶[268]。因此,在高度近视中,视盘旁边缘组织可能对青光眼易感性的增加有一定的重要性。
最近的一项临床研究结果也与组织学和基于人群的调查结果一致,显示青光眼性视神经病变的患病率随眼轴长度的增加逐渐升高,眼轴长度<26.5、26.5~27.9、28.0~28.9和29.0~29.9 mm时,患病率分别约为12.0%、28.5%、32.6%和36.0%,眼轴长度≥30.0 mm时患病率升至42.1%[252]。在调整眼轴长度后,较高的青光眼患病率与较大的Δ区及视盘相关。这些结果表明,在临床上发现有大的视盘和/或大的Δ区时,应高度怀疑高度近视合并青光眼视神经损伤。
从实际角度来看,青光眼视神经损伤的检测随着眼轴长度的增加而变得更加困难。眼轴增长导致生理性视盘变大,使神经视网膜边缘和视杯底部的高度差减小,描绘杯/盘缘的轮廓更加困难[269,270]。此外,视盘边缘的粉红色变淡,使视盘缘和视杯的颜色对比下降。视盘旁区域亮度增加,主要是γ区和Δ区,降低了神经视网膜纤维层的可检性,这2个区域的出现使青光眼相关β区检测困难。此外,伴有青光眼性视神经病变的高度近视眼的眼压往往在正常范围内,周边视野缺损往往不典型,这可能是由屈光异常、近视性黄斑病变和/或非青光眼性视神经损害引起的[271]。在检眼镜下,高度近视眼伴随青光眼性视神经损伤的最重要体征可能是发现视盘内血管迂曲相对接近于视盘边缘,以致于神经视网膜缘的形状不符合ISNT原则[252,260]。
青光眼进展的检测与青光眼存在的检测相比更加困难,特别是高度近视眼。观察周边视野的改变可能有助于检测青光眼的进展,因为大多数其他的心理物理和形态测量技术都不可行。
虽然高度近视眼的青光眼视神经病变可通过视盘内血管迂曲相对接近于视盘边缘来界定,但缺乏相关研究证据,表明这种视神经损伤的效应与眼压的相关性[271]。因此,可以说是青光眼或青光眼样视神经病变[252]。此外,在颞侧有较大γ区的眼可能存在非青光眼性视神经损伤。在最近的一项基于人群的研究中,高度近视或近视性黄斑病变的高患病率与排除青光眼后的视网膜神经纤维层变薄相关[250]。高度近视而无Ⅲ或Ⅳ类近视性黄斑病变并且无青光眼样视盘的患者可表现为中心暗点扩大,与临床观察相吻合。可以认为,由于γ区的增大,导致视盘和中央凹之间的距离变长,以及最终的黄斑区视网膜神经节细胞轴突的拉伸以及丢失。这种机制可能与青光眼视神经损伤相似。目前仍不清楚近视牵引性黄斑病变患者内界膜牵拉视网膜神经节细胞层而相对缩短视网膜神经节细胞和视盘之间的距离,是否可以部分保护高度近视眼的非青光眼性视神经损害。如果这个推测是正确的,且考虑行近视性黄斑病变手术治疗,应该考虑这个因素。
总之,高度近视眼的青光眼性视神经病变的患病率随着眼轴增长而增加,可超过50%。因此,对于任何有高度近视的眼,尤其是那些有继发性扩大的视盘和大的视盘旁Δ区的眼,都应该排除青光眼。
在过去的20年里,OCT极大地提高了我们对各种视网膜病变的认识。近年来OCT技术的发展,包括增强深度成像OCT和扫频OCT,为高度近视眼的脉络膜提供了高分辨率的图像和高度可靠的脉络膜测量。众所周知,高度近视眼的脉络膜明显更薄[7,87,112,113,136,272,273,274,275,276,277,278,279,280,281,282,283,284,285,286]。以往的研究均支持脉络膜变薄可能在近视性黄斑病变的发病机制中起重要作用的理论。此外,扫频OCT显示局限性萎缩和近视MNV相关的黄斑萎缩不是单纯的萎缩,而是黄斑区Bruch膜缺陷[117,120,287]。进一步来说,OCT还能检测到眼底照相无法识别的新的黄斑病变,如近视牵引性黄斑病变和圆顶状黄斑。
虽然META-PM分型非常有用,但弥漫性萎缩的诊断仅依赖于其在检眼镜下呈现的黄色外观。但不同种族眼底色素沉着程度不同,眼底颜色也可能不同,这可能影响萎缩性病变的准确诊断。早期的研究表明,弥漫性萎缩的特征是OCT图像中脉络膜极薄(几乎没有全层脉络膜)[7,112,113,288]。因此,将脉络膜厚度加入到分型中可以使诊断变得更加客观和准确。此外,其他仅能通过OCT诊断的近视性黄斑病变,如近视牵引性黄斑病变和圆顶状黄斑,可以纳入基于OCT的近视性黄斑病变分类(表4)。

基于OCT的近视性黄斑病变的分类
基于OCT的近视性黄斑病变的分类
| 近视性黄斑病变的阶段 | 新术语 | 详细描述 | 旧术语 |
|---|---|---|---|
| Ⅰa | 视盘旁脉络膜变薄 | 中心凹鼻侧3 000 μm,脉络膜厚度<56.5 μm,在γ区外侧 | PDCA |
| Ⅰb | 黄斑区脉络膜变薄 | 中心凹下脉络膜厚度<62 μm | MDCA |
| 附加体征 | 线性Bruch膜缺损 | 黄色线性病变。OCT图像显示RPE不连续,RPE外深层组织超传导增加 | 漆裂纹 |
| Ⅱ | 中心凹外Bruch膜缺损 | 黄斑区、中心凹外区域边界清晰的灰白色圆形病变。Bruch膜缺损被细小的增宽的RPE缺损环绕,RPE缺损的大小和形状决定了检眼镜下病变的大小和形状。在Bruch膜缺损区域,视网膜外层、RPE、脉络膜毛细血管层和脉络膜中间大血管层大部分缺损,脉络膜中间血管层或大血管层可能偶尔存在。视网膜的中间和内层或多或少变薄,与巩膜内表面直接接触 | 局限性萎缩 |
| 附加体征 | 近视性CNV | 眼内发生CNV,至少视盘旁或黄斑区脉络膜变薄 | CNV |
| Ⅲ | 中心凹Bruch膜缺损 | OCT组织学和中心凹外Bruch膜缺损一致 | 黄斑区萎缩 |
| Ⅲb | 中心凹Bruch膜缺损,CNV相关 | 边界清楚的圆形病变,包括中心凹和围绕中心凹扩大的区域。黄斑区Bruch膜缺损的边缘常常上卷。在中央有Bruch膜的残留物,在RPE相关的瘢痕形成过程中内卷 | CNV相关的黄斑区萎缩 |
| Ⅲa | 中心凹Bruch膜缺损,局限性相关 | 在中心凹外侧区域发生和向中心凹方向扩大,或与中心凹外的其他Bruch膜缺损向中心凹方向融合 | 局限性相关的黄斑区萎缩 |
| 附加体征 | 黄斑牵引性黄斑病变 | 劈裂样内层视网膜裂开,劈裂样外层视网膜裂开,中心凹脱落,板层或全层黄斑裂孔和/或黄斑脱落 | |
| 附加体征 | 圆拱形黄斑和黄斑脊 | 在所有的径线上,RPE线性圆拱样、向内的隆起,高于基线>50 μm,基线在圆拱外面的两侧与RPE相连。黄斑脊:RPE线性向内的隆起,在水平和垂直扫描高度都大于基线50 μm以上,RPE线与基线相连 |
注:OCT:光学相干断层扫描;CNV:脉络膜新生血管;RPE:视网膜色素上皮;PDCA:乳头周围弥漫性脉络膜萎缩;MDCA:黄斑区弥漫性脉络膜萎缩
众所周知,高度近视眼的脉络膜比正常眼要薄[7,87,112,113,136,272,273,274,275,276,277,278,279,280,281,282,283,284,285,286]。病理性近视眼(定义为等同于或比弥漫性萎缩更严重的近视眼)的脉络膜极薄。在许多病例中,几乎整个脉络膜的厚度消失,偶尔保留较大的脉络膜血管[7,288]。
在儿童时期,从颞侧到视盘,脉络膜开始明显变薄,称为PDCA[30]。高度近视儿童中存在PDCA被认为是最终发展为晚期近视性黄斑病变的1个指标[30]。在OCT图像上,儿童PDCA的特征是在颞侧视盘旁区域的脉络膜厚度突然明显变薄[289]。脉络膜变薄是突然的和局限性的;因此,其与脉络膜循环的广泛受损截然不同。随后,Yokoi等[289]还比较了基于医院病例的高度近视儿童伴PDCA组与基于人群的儿童对照组之间的OCT结果,发现在PDCA组中,有76%患者从鼻侧向中央凹方向外2 500 μm处的脉络膜厚度变薄了60 μm,在对照组中未发现此现象[289]。提示该脉络膜厚度的潜在临界值可能有助于检测和诊断近视儿童的PDCA。随着时间的推移,脉络膜极度变薄的区域会扩大,这被认为是MDCA[77]。
在一项高度近视眼的组织学研究中报道了黄斑区Bruch膜缺陷[121]。这些黄斑区Bruch膜缺陷伴随着RPE和脉络膜毛细血管层的完全丧失,视网膜外层和中间层以及中等大小的脉络膜血管层几乎完全丧失。随后,利用扫频OCT发现病理性近视的Bruch膜缺损与2种不同的黄斑病变有关,即近视MNV相关的黄斑萎缩和局限性萎缩[117,120,287]。这些研究表明,以前认为局限性萎缩和MNV相关的黄斑萎缩是脉络膜视网膜萎缩,而现在发现它们不是简单的萎缩,而是Bruch膜裂孔。
漆裂纹也被认为是Bruch膜的破裂;然而,由于病变往往过于窄小,OCT难以检测到该缺陷。在某些情况下,漆裂纹中可以观察到RPE的不连续性,甚至深达RPE以外更深层次的组织。
近视牵引性黄斑病变[290,291]和圆顶状黄斑[207]是病理性近视最常见的并发症。OCT是诊断这2种疾病不可或缺的工具,尽管在少数情况下,检眼镜也可以发现这些病变。近视牵引性黄斑病变一般通过OCT检查来确诊,包括劈裂样视网膜内液、劈裂样视网膜外液、中央凹脱离、板层或全层黄斑裂孔和/或黄斑脱离[292]。Gaucher等[207]最初发现圆顶状黄斑是采用OCT描述为葡萄肿内黄斑区域向内的突起,这可能是近视患者视力丧失的原因。根据以下广义的定义,无论垂直或水平扫描,在最凸处的扫描中黄斑隆起高度>50 μm均可定量诊断为圆顶状黄斑。
近视性黄斑病变的脉络膜厚度分布不同于高度近视伴正常眼底。目前有3项基于META-PM分类的研究说明了脉络膜厚度与近视性黄斑病变不同病变之间的关系(图19)[7,113,136]。采用扫频OCT对高度近视患者1 487眼进行了横断面研究[7],发现眼底正常的高度近视眼的中央凹下脉络膜厚度在水平扫描时最厚,与非高度近视眼一样[293]。相比之下,在近视性黄斑病变中(即等同于豹纹状眼底或更高的类别),颞侧脉络膜最厚。在垂直扫描中,正常眼底的下方脉络膜最薄,而在近视性黄斑病变的眼中,中央凹下脉络膜最薄。这一结果也在另一项比较豹纹状眼底和正常眼底脉络膜厚度的研究中得到证实,表明有相同的垂直扫描结果[114]。豹纹状眼底的脉络膜厚度分布模式甚至与其他更高类别的近视性黄斑病变相同,如PDCA、MDCA和局限性萎缩。这一发现提示,豹纹状眼底可能是近视变为病理性的首个标志。


研究显示,平均中央凹下脉络膜厚度在正常眼底是274.5 μm,豹纹状眼底为129.1 μm,PDCA为84.6 μm,MDCA为50.2 μm,局限性萎缩为48.6 μm,MNV相关的黄斑萎缩为27.3 μm,局限性相关的黄斑萎缩为3.5 μm(图20)[7]。随着近视性黄斑病变的加重,所有部位的脉络膜厚度均下降,从正常眼底到豹纹状眼底、再到PDCA和MDCA。但除鼻侧外,MDCA和局限性萎缩之间其余各处的脉络膜厚度无显著差异。由于另外2项研究没有把PDCA从MDCA中区分开来,因此弥漫性萎缩的脉络膜厚度明显比局限性萎缩厚,这是合理的,而弥漫性萎缩可能包括PDCA和MDCA[113,136]。


黄斑萎缩(包括MNV相关和局限性相关,或两者都有)的中央凹下脉络膜厚度薄于其他组[7]。局限性相关黄斑萎缩的中央凹下脉络膜厚度甚至比MNV相关黄斑萎缩患者的脉络膜厚度更薄。值得注意的是,MNV相关的黄斑萎缩、MDCA和局限性黄斑萎缩在颞侧、鼻侧、上方和下方的脉络膜厚度上没有差异。
另外2项研究结果也显示,脉络膜厚度与近视性黄斑病变的严重程度呈负相关[113,136]。中山眼科中心一项对高度近视的临床研究[113]调查了大规模人群的脉络膜厚度。在该研究中,正常眼底(C0)、豹纹状眼底(C1)、弥漫性萎缩(C2)、局限性萎缩(C3)和黄斑萎缩(C4)平均中央凹下脉络膜厚度分别为165、80、49、35和6.5 μm。研究还发现,C0~C4类随着黄斑病变程度的加重,视网膜中央凹下脉络膜厚度显著变薄,但C3~C4类视网膜中央凹旁脉络膜厚度相似。由此得出结论,C4不是C3进展的结果,这与Fang等[77]的长期随访研究一致。
Fang等[7]利用受试者工作特征曲线和约登指数(也称正确指数)确定了诊断PDCA的鼻侧脉络膜厚度(中央凹外3 000 μm),其最佳临界值为56.5 μm。尤其适用于20岁以下年龄组的诊断,灵敏度高达90%,特异度为88%。在老年组,各方向上的脉络膜厚度曲线下面积减小。对于60~79岁组,只有中央凹下脉络膜厚度可用于诊断。
鼻侧脉络膜厚度不能区分PDCA和MDCA。相反,脉络膜厚度的临界值在视网膜中央凹下、颞侧、上方、下方分别选择62、73、83、84.5 μm(敏感度分别为71%、67%、67%、81%,特异度分别为72%、90%、80%、65%)时,可用于区分MDCA[7]。虽然中央凹下脉络膜厚度的曲线下面积在所有方向上不是最大的,但是临界值仍以中央凹下脉络膜厚度为参考,是因为中央凹下脉络膜厚度的测量比中央凹旁的测量更容易和更准确。
结合病理性近视中近视性黄斑病变的特征,提出了一种基于OCT结果的新分类。在这个新的系统中,对于PDCA和MDCA,弥漫性脉络膜萎缩被建议称为"视盘旁脉络膜变薄"和"黄斑区脉络膜变薄"(表4)。基于这些结果,该系统增加了作为弥漫性萎缩诊断工具的脉络膜厚度的临界值。即视盘旁脉络膜变薄被定义为距中央凹3 000 μm的鼻侧脉络膜厚度<56.5 μm;黄斑区脉络膜变薄被定义为中央凹下脉络膜厚度<62 μm。局限性萎缩和MNV相关的黄斑萎缩不仅仅是由于萎缩,还是由于Bruch膜上的孔。局限性萎缩在眼底照像上是一种界限清楚的灰白色病变,很少累及中央凹,OCT下很适合被称为"中央凹外Bruch膜缺陷"。相比之下,中央凹Bruch膜缺陷因黄斑萎缩而命名,即META-PM分类中的第4类,包括MNV相关性疾病和局限性相关性疾病。此外,近视牵引性黄斑病变和圆顶状黄斑病变均为潜在的威胁视力的黄斑并发症,只有通过OCT才能检测出,也被纳入基于OCT的近视性黄斑病变分类。
从单纯高度近视的临床研究中得出的脉络膜厚度临界值是否具有良好的临床应用价值尚需进一步验证。更多的研究不仅要通过测量脉络膜的厚度,还应通过检查脉络膜的血流和脉络膜的形态及血管特征等其他参数来研究脉络膜在高度近视中的作用。对脉络膜变化的纵向研究将有助于我们描绘高度近视患者脉络膜变化的真实图画。
病理性近视的诊断和治疗方法都有了很大的进步。特别是,抗VEGF治疗和玻璃体视网膜手术改善了近视性MNV和近视牵引性黄斑病变的解剖和视力结果。然而,治疗方法并不足以治疗其他并发症,如脉络膜萎缩和视神经损伤。由于视盘的外观畸形以及近视性黄斑病变和一个大的γ区产生的暗点,青光眼在病理性近视眼中很难诊断。因为视神经损伤被认为是病理性近视致盲的重要原因,今后的工作应关注对病理性近视患者进行青光眼的早期诊断。
后巩膜葡萄肿导致包含黄斑和视神经在内的视觉重要组织区域变形。与之形成对比的是,普通近视的大多数眼轴增长发生在眼的赤道部。因此,后巩膜葡萄肿的形成会机械地损害这些神经组织。在出现不可逆的致盲并发症之前,预期采取的方法是预防和治疗葡萄肿。
最后,明确哪些基因与病理性近视(非高度近视)相关是很重要的。有了这些基因信息,我们将清楚地知道病理性近视是否不同于普通近视。此外,也有可能区分哪些儿童将患病理性近视。
基于病理性近视的一致性定义及其客观检查的主要特征——后巩膜葡萄肿,未来应开展关于病理性近视全球患病率及其对视力和生活质量影响的研究[294]。
(略)
国际近视研究院报告的出版费用由布赖恩·霍尔顿视觉研究所、卡尔·蔡司视觉、库博视觉、依视路和爱尔康的捐款支持;本文所有作者均声明不存在利益冲突
感谢Monica Jong对这篇报告的鼎力相助;感谢国际近视研究院支持